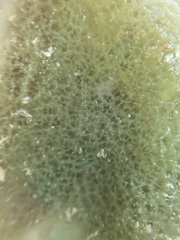
Amphimedon viridis

Amphimedon viridis: taxon details and analytics
- Domain
- Kingdom
- Animalia
- Phylum
- Porifera
- Class
- Demospongiae
- Order
- Haplosclerida
- Family
- Niphatidae
- Genus
- Amphimedon
- Species
- Amphimedon viridis
- Scientific Name
- Amphimedon viridis
Summary description from Wikipedia:
Amphimedon viridis
Amphimedon viridis is een sponssoort in de taxonomische indeling van de gewone sponzen (Demospongiae). Het lichaam van de spons bestaat uit kiezelnaalden en sponginevezels, en is in staat om veel water op te nemen.
De spons behoort tot het geslacht Amphimedon en behoort tot de familie Niphatidae. De wetenschappelijke naam van de soort werd voor het eerst geldig gepubliceerd in 1864 door Duchassaing & Michelotti.
...Images from inaturalist.org observations:
We recommend you sign up for this excellent, free service.